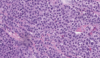

Testicule - AMBM Flashcards
(83 cards)
Quelles sont les deux types de cellules retrouvées dans les tubules séminifères ?
- Cellules germinales (90%)
- Cellules de Sertoli
Quel est le défaut congénital le plus fréquent touchant le testicule ?
Cryptorchidie
Quelles sont les deux phases de la descente normale des testicules ?
- Transabdominale (contrôlée par l’AMH)
- Inguinoscrotale (contrôlée par les androgènes)
Quelle est l’incidence de la cryptorchidie ?
- 3% (naissance à terme) ad 30% (prématurés)
- Seulement 1% à un an (auto-résolutif dans la majorité des cas)
Quel est le principal site d’arrêt de la descente du testicule ?
Canal inguinal
Quelles sont les possibles complications de la cryptorchidie ?
- Cancer du testicule (RR 3 à 5)
- Torsion/infarctus testiculaire
- Hernies inguinales
- Infertilité
Que devrions-nous rechercher lors de l’examen histologique des spécimens d’orchidopexie dans un contexte de cryptorchidie ?
Néoplasie germinale in situ
Quels sont les changements histologiques possibles lors d’une cryptorchidie ?
- Diminution spermatogénèse
- Atrophie tubulaire jusqu’à la sclérose
- Appauvrissement en cellules Sertoli
- Cellules Leydig semblent plus proéminentes (car non touchées)
- Épaississement membrane basale des tubules
- Fibrose interstitielle
- +/- GCNIS
Pourquoi faut-il inscrire au rapport s’il y a atteinte du rete testis ?
Pourrait être associé à un risque augmenté de récidive (dans le séminome)
Considéré tout de même comme limité au testicule (T1)
Qu’est-ce qui représente une atteinte du rete testis ?
Tumeur dans le stroma du rete testis +/- atteinte lumière
Pas seulement une extension pagétoïde GCNIS
Quels sont les prélèvements recommandés au niveau du cordon spermatique et pourquoi est-ce important ?
- Marge du cordon spermatique
- Section moyenne
- Section à la base
Important car atteinte continue du cordon à partir du testicule représente T3
Nomme les prélèvements importants à prendre en macroscopie lors d’une tumeur testiculaire ?
- Cordon spermatique (marge, section moyenne, section base)
- Tumeur (# selon grosseur)
- Tissus mous du hile testiculaire
- Épididyme
- Testicule non-atteint
- Autres lésions
- Ganglions (si soumis)
Nomme des causes de granulomes au testicule
- Causes infectieuses (fungiques ou mycobactériennes)
- Tumorale (séminome)
- Auto-immune
- Traumatique
- Extravasation sperme
- Compromis vasculaire
Quelle orchite infectieuse commence au testicule sans atteindre, du moins initialement, l’épididyme ?
Orchite syphilitique
Qu’est-ce qui détermine principalement le T du TNM du testicule ?
Étendu tumoral (limité au testicule ou atteinte du hile, épididyme, tunique albuginée, cordon spermatique, scrotum)
et selon présence/absence LVI
+/- la taille si T1 séminome pure

Quel groupe de tumeur représente la très grande majorité des cancers du testicule ?
Tumeurs germinales (> 90%)
Généralement les patients sont plus jeunes dans les tumeurs germinales séminomateuses ou non-séminomateuses ?
Non-séminomateuse
Âge médian au diagnostic:
* Séminome: 37 ans
* Non-séminome: 30 ans
Pourquoi il n’est pas recommandé de procéder à une biopsie pour confirmer une lésion tumorale ?
Risque important d’essaimage
Quel est le risque de progression de la GCNIS vers une tumeur germinale invasive ?
70% à 7 ans
En quel sous-type de tumeur germinale évolue habituellement la GCNIS ?
Possible progression en n’importe quel sous-type (Impossible de prédire)
Quel est le patron d’extension le plus fréquent de la GCNIS ?
Extension pagétoïde (string of beads)
Qu’entraine la présence de GCNIS sur la spermatogénèse ?
Diminution importante de la spermatogénèse
Quelle altération moléculaire additionnelle est normalement acquise par les cellules de la GCNIS dans le développement d’une tumeur germinale maligne ?
Gain d’un isochromosome 12p
Quelles tumeurs germinales ne sont pas associées à la GCNIS ?
- Tumeur spermatocytaire
- Tératome pré-pubertaire
- Tumeur du sinus endodermique pré-pubertaires
- Tumeur neuroendocrine testiculaire de type pré-pubertaire
- Tératome et tumeur du sinus endodermique pré-pubertaires mixte